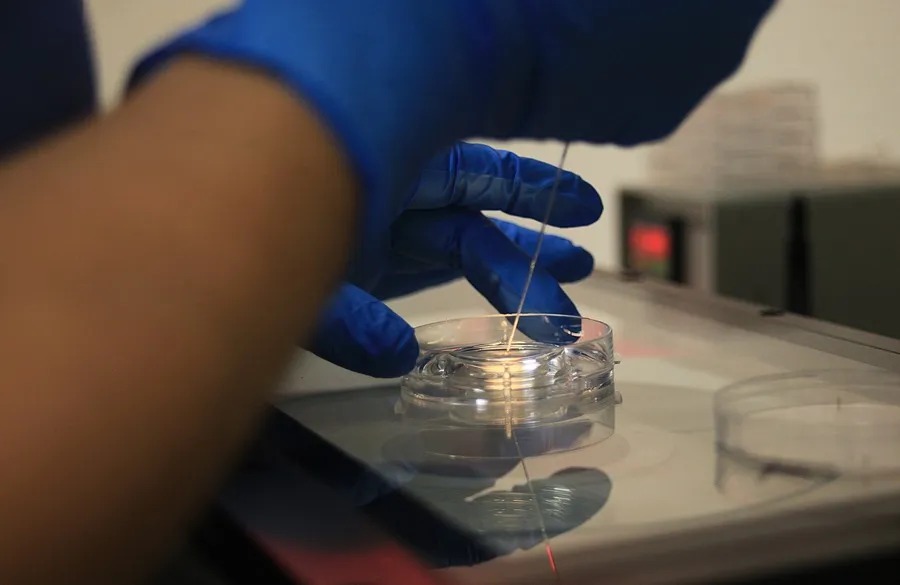

Internacional > Ciencias
Efe
13/06/2024 | Pekín, China
Un equipo científico chino encontró microplásticos en 40 muestras de semen, identificándose ocho polímeros distintos, siendo el poliestireno (31 por ciento) el más prevalente.
Las conclusiones del estudio, alineadas con una investigación previa del mismo grupo, se publican en la revista Science of The Total Environment.
Los microplásticos son contaminantes ambientales omnipresentes que se han detectado en el semen humano procedente de zonas contaminadas, pero su prevalencia y efectos en la población general siguen siendo en gran medida inexplorados, relatan los autores en su artículo.
Recogida de muestras en China
Para examinar la presencia de estos, su abundancia, los tipos de polímeros y las asociaciones con los parámetros de calidad del semen en individuos -sin exposición ocupacional-, este trabajo se llevó a cabo mediante la recogida de muestras de semen de 40 participantes en Jinan, China.
Se empleó la microespectroscopia Raman para identificar, cuantificar y categorizar los polímeros microplásticos; se evaluó la motilidad espermática mediante análisis asistido por ordenador y se evaluó la morfología.
Foto: Efe
Mediante análisis estadístico se examinaron las correlaciones entre los datos demográficos, los parámetros del semen y el contenido de microplásticos.
Los investigadores de la Universidad de Qingdao detectaron microplásticos en todas las muestras de semen, con dos partículas por muestra.
Identificados ocho polímeros distintos
Se identificaron ocho polímeros distintos, siendo el poliestireno (31 por ciento), el polietileno (14 por ciento) y el cloruro de polivinilo (PVC, 14 por ciento) los más prevalentes.
El semen expuesto al poliestireno mostró una mayor motilidad progresiva de los espermatozoides en comparación con el grupo expuesto al cloruro de polivinilo. Se observaron anomalías morfológicas en los espermatozoides, pero no se asociaron significativamente a tipos de plástico específicos.
No obstante, los efectos de la exposición a diferentes polímeros microplásticos sobre la motilidad progresiva de los espermatozoides variaron.
Afectan a la fertilidad masculina
Esto, según los autores, subraya la necesidad de seguir investigando cómo los microplásticos afectan la fertilidad masculina en términos de su presencia generalizada y su posible toxicidad reproductiva.
La ciencia estudia hace décadas el efecto de la contaminación por microplásticos en la salud humana y cómo estos residuos acaban penetrando en el cuerpo y con ellos los tóxicos que puedan contener.
Aunque aún queda mucho por saber, algunas evidencias señalan su presencia en la placenta y la leche materna, el torrente sanguíneo, la profundidad de los pulmones o el cerebro.
Edición: Estefanía Cardeña